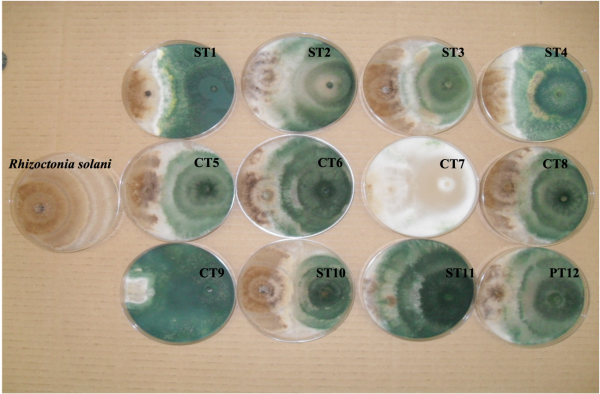

En la agricultura actual los hongos y las bacterias no son sinónimo de enfermedad. Miles de productos están compuestos por estos microorganismos para enriquecer los suelos y conseguir plantas más resistentes frente a enfermedades y estreses como la sequía.

Finca experimental de cereales del INIA-CSIC donde se analizan desde hace 30 años diferentes prácticas de manejo agrícola para incrementar el secuestro de carbono en el suelo. / Marta Goberna. Fuente: Agencia Sinc
Son las seis de la mañana. El agricultor Francisco López comienza como cada día las labores de la finca almeriense ecológica de pepinos y berenjenas en la que lleva más de 40 años trabajando. Como si del laboratorio de Dexter se tratara, prepara un coctel de hongos, bacterias y otros compuestos que luego vierte en sus suelos.
Este combinado que López elabora a pequeña escala se asemeja a los miles de productos comerciales que se utilizan cada vez con más frecuencia en la agricultura para impulsar el crecimiento de las plantas de manera ecológica. Es decir, productos basados en microorganismos que mejoran la producción, protegen a las plantas frente a las enfermedades e, incluso, las fortalece frente a situaciones estresantes como la sequía.
“Los microorganismos y la materia orgánica favorecen la fertilidad del suelo. Cuanto más fértil sea, mejor se desarrollarán las plantas que hay en él”, asegura el agricultor. Sin embargo, la enorme diversidad de microorganismos y las funciones que desempeñan en el suelo no se conocían hasta hace poco.
“Sabíamos que en el suelo había microorganismos y que algunos de ellos podían ser beneficiosos, pero no cuáles había exactamente, qué importancia tenían unos géneros con respecto a otros, ni cómo interaccionaban entre ellos”, explica a SINC Carmen Gómez-Lama, experta en interacciones planta-microorganismos e investigadora en el Instituto de Agricultura Sostenible (IAS-CSIC).
Sabíamos que en el suelo había microorganismos y que algunos de ellos podían ser beneficiosos, pero no cuáles había exactamente
Carmen Gómez-Lama del IAS-CSIC
Esta información salió a la luz con la llegada de las técnicas de secuenciación masiva de ADN o metagenómica, que permitieron conocer en profundidad la diversidad microbiana que merodeaba entre hojas, raíces y frutos.
“Estas técnicas se han extendido desde inicios del siglo XXI y han sido una revolución. Nos permiten estudiar todos los genes que componen una comunidad de manera rápida, identificar quién vive en el suelo y cuáles son sus posibles funciones. Esta metodología nos ha ayudado a ver el suelo como un ecosistema que alberga muchísima vida y no como un mero soporte físico inerte para sostener la vegetación”, señala a SINC la investigadora del Instituto Nacional de Investigación y Tecnología Agraria y Alimentaria (INIA-CSIC), Marta Goberna.
La experta en microbiota edáfica detalla que “en un gramo de suelo, que equivale aproximadamente a una cucharilla de café, hay millones de individuos que pertenecen a miles de taxones diferentes”.
En un gramo de suelo, que equivale aproximadamente a una cucharilla de café, hay millones de individuos que pertenecen a miles de taxones diferentes
Marta Goberna, del INIA-CSIC
Es algo similar a lo que ha ocurrido con el microbioma intestinal de los humanos. “Sabíamos que había bacterias y hongos en nuestro intestino, pero no conocíamos cómo interactuaban entre ellos, cuáles eran los buenos y los malos ni su efecto concreto en nuestra salud”, observa José Miguel Mulet, catedrático de biotecnología de la Universidad Politécnica de Valencia.
Mineros en descomposición del fosfato
Todos estos microorganismos actúan como mozos que trabajan para que la planta pueda alimentarse de los macronutrientes que necesita para crecer: nitrógeno, fósforo y potasio.
“El fosfato, por ejemplo, es un elemento muy insoluble y, por tanto, difícil de absorber para las plantas. Las bacterias lo convierten en fosfato orgánico mediante reacciones químicas y esto hace que la planta lo pueda asimilar”, describe el experto en biología molecular.
En este proceso se establece una relación simbiótica en la que todos los implicados se benefician: “La planta hace la fotosíntesis y segrega al suelo azúcares que sirven de alimento a la bacteria. Es decir, intercambian fosfato por carbono y ambas se aprovechan del proceso”, aclara Mulet. Así trabajan algunas bacterias como las Pseudomonas putida o Bacillus, etc.
Además, a veces estas bacterias actúan como antagonistas de los patógenos: “Si matas todas las bacterias del suelo con un producto químico, corres el riesgo de que un patógeno crezca. Sin embargo, si aumentas el número de bacterias beneficiosas, cuando venga un patógeno no le quedará sitio”, manifiesta.
Si matas todas las bacterias del suelo con un producto químico, corres el riesgo de que un patógeno crezca
José Miguel Mulet, de la Universidad Politécnica de Valencia
La ciencia también trabaja con bacterias que solubilizan el potasio y otros minerales como el hierro o el magnesio, aunque por el momento es una práctica menos extendida.
Por otro lado, hay bacterias que ayudan a fijar el nitrógeno atmosférico al tomar directamente el nitrógeno del aire, lo que origina compuestos susceptibles de incorporarse a la composición del suelo o de los seres vivos. Esto responde a la problemática actual de exceso de nitrógeno químico en la agricultura, que puede alterar los ecosistemas naturales, causando acidificación, desequilibrio de nutrientes y pérdida de biodiversidad.
Antagonismo de 12 cepas del hongo Trichoderma harzianum contra el fitopatógeno Rhizoctonia solani. / Rosa Hermosa. Fuente: Agencia Sinc
Hongos y micorrizas contra la sequía
Los hongos son otros de los microorganismos más utilizados en los suelos agrícolas. “Concretamente, el hongo más utilizado en agricultura a escala mundial es del género Trichoderma, que se utiliza frente a otros hongos patógenos y para mejorar la tolerancia de las plantas frente a la sequía o la salinidad”, mantiene Rosa Hermosa, catedrática de microbiología de la Universidad de Salamanca y pionera en España en el estudio de la respuesta de plantas a Trichoderma, un hongo ampliamente utilizado como agente de control biológico contra diversos patógenos vegetales.
El aumento de su uso, que ha pasado de 21 productos comerciales registrados a 144 en cuarenta países, demuestra su interés en la agricultura. La investigadora fue autora de la patente del primer biofungicida español y desde entonces sigue rastreando las cualidades de este género.
El hongo más utilizado en agricultura a escala mundial es del género Trichoderma, que se utiliza frente a otros hongos patógenos
Rosa Hermosa, de la Universidad de Salamanca
Todos estos mecanismos ejecutados por hongos y bacterias mejoran la disponibilidad de nutrientes para las plantas y las fortalecen frente a la sequía, la sal o las enfermedades producidas por organismos vivos. Todo ello puede promover una mejora del rendimiento de los cultivos.
Ventajas similares ocurren con las micorrizas, que se definen como la simbiosis entre un hongo y las raíces de una planta. En esta relación el hongo ayuda a prolongar las raíces de la planta y aumenta la solubilización de fósforo y la captura de nitrógeno, permitiendo a la planta hacer un uso más eficiente del agua y los nutrientes.
Regulación de productos naturales
Uno de los problemas a los que se enfrentan todavía los productos basados en microorganismos es la regulación actual “porque la regulación de fitosanitarios basados en microorganismos es más compleja y lenta que la de fitosanitarios químicos debido a la complejidad biológica, la variabilidad genética, las interacciones ambientales, la falta de estándares unificados, la necesidad de métodos de prueba específicos y el relativamente limitado conocimiento en comparación con los productos químicos. En la Unión Europea, se aplica el principio de precaución, lo que implica una evaluación más rigurosa y basada en evidencia científica para garantizar altos niveles de seguridad y protección ambiental”, declara Gómez-Lama.
De hecho, la experta señala que esta práctica “está más extendida en Asia y Latinoamérica, donde la regulación no es tan estricta. En España, además, muchos de estos productos se registran como biofertilizantes porque la normativa es mucho más sencilla que la de los fitosanitarios”.
Muchos de estos productos se elaboran con microorganismos procedentes de países como Estados Unidos o la India, por lo que necesitamos saber cómo se adaptan
Mario Javier Ruiz, de la UPV
Es posible que en el futuro entren en juego más factores a la hora de autorizar estos productos, como la procedencia de los microorganismos que contienen. “Muchos de estos productos se elaboran con microorganismos procedentes de países como Estados Unidos o la India, por lo que necesitamos saber cómo se adaptan e interaccionan con otros ambientes y confirmar que no los alteran”, apunta a SINC Mario Javier Ruiz, investigador del Instituto Universitario de Conservación y Mejora de la Agrodiversidad Valenciana de la UPV.
El científico recuerda que la Comunidad Europea está abanderando proyectos que persiguen la regeneración de los suelos: “El objetivo es frenar la liberación de CO2 que producen los suelos degradados e impulsar la absorción, por parte de suelos vivos, de este dañino compuesto para el planeta”.
Un ingrediente de la agricultura ecológica
Estos productos son una alternativa a los fertilizantes y fitosanitarios químicos en el contexto actual de crecimiento de agricultura ecológica. “Los fertilizantes químicos están muy bien estudiados y maximizan la producción. Sin embargo, hemos comprobado que es contraproducente para la salud, tanto de los suelos como del planeta”, expone.
“Además, los fitosanitarios químicos evitan el crecimiento de enfermedades que suelen ser producidas por microorganismos, pero también impactan negativamente sobre los microorganismos beneficiosos, alterando el equilibrio natural del suelo”, añade.
Los suelos están muy quemados por el boom de los químicos. Necesitamos enriquecerlos con materia orgánica para que los microorganismos puedan alimentarse y sobrevivir
Mario Javier Ruiz
El agricultor almeriense comparte esta postura ya que su experiencia le hizo pasar por un difícil periodo para conseguir que en su suelo recobrase vida. “Los suelos están muy quemados por el boom de los químicos. Necesitamos enriquecerlos con materia orgánica para que los microorganismos puedan alimentarse y sobrevivir. Es importante lograr ese equilibrio y, cuando sea necesario, ayudar a la naturaleza regalándole un extra de microorganismos para compensar el agitado ritmo al que le obligamos a producir”, recuerda Francisco López, que trata de mantener el equilibrio en sus cultivos y comprar los mínimos productos posibles.
“Debemos implementar prácticas de manejo que nos permitan mantener un suelo fértil y con estructura, que esté aireado y poroso, para lograr un sistema que albergue comunidades biológicas abundantes y diversas donde las plantas puedan crecer bien. En paralelo al uso de este tipo de prácticas regenerativas, también nos podremos plantear utilizar insumos basados en microorganismos beneficios que sean seguros para el medio ambiente y económicamente viables”, concuerda Marta Goberna.
Fuente: Agencia Sinc

Deja tu comentario